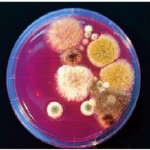
R
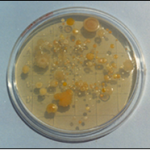
en

ENVIROCOUNT® (Placas de Contacto): El Estándar Superior para Control de Higiene
Las Placas de Contacto ENVIROCOUNT® (nuestra denominación para las placas RODAC con medio convexo) son el método más fiable y reproducible para el control microbiológico ambiental.
Hemos optimizado el diseño y la fabricación para ofrecer doble esterilidad, máxima vida útil y neutralización total de residuos desinfectantes.
Ventajas Técnicas y Superioridad Comprobada
Diseño Exclusivo: Doble Esterilidad y Triple Envuelta
Nuestras placas de con fondo cuadriculado se diferencian por procesos de fabricación únicos que garantizan la calidad y seguridad:
- Doble Esterilidad (Irradiación Gamma): Tras ser elaboradas, las placas se esterilizan por segunda vez con radiación Gamma.
- Resultado: Garantía de ausencia total de placas contaminadas.
- El aire de la envuelta también es estéril, previniendo la contaminación por fugas durante el transporte.
- Triple Envuelta y Antidesecación: Desde 2013, se envasan con triple envuelta de plástico y contienen gel antidesecación.
- Resultado: Caducidad real muy superior a la de cualquier otra marca, resistiendo incluso muestreos de impacto de aire de hasta litros.
Neutralización Total (Máxima Recuperación)
Las placas ENVIROCOUNT® son las únicas con inactivadores para todo tipo de residuos, garantizando que estos agentes no inhiban el crecimiento microbiano:
- Agentes Neutralizados: Derivados de amonio cuaternario, fenoles, formol, glutaraldehído, compuestos mercuriales, iodo, cloro-lejía, etc.
Uso en Zonas Estériles
El proceso de doble esterilidad permite un uso seguro en ambientes controlados:
- Retirar la primera envuelta antes de entrar en zona estéril.
- Retirar la segunda envuelta (estéril por dentro) en la zona limpia.
- Retirar la tercera envuelta (estéril por dentro y por fuera) en la esclusa.
Gama de Medios de Cultivo Clave
Ofrecemos las placas ENVIROCOUNT® con los medios más recomendados para el control ambiental:
Modo de Empleo y Recomendaciones
Para Superficies
- Aplicar el agar sobre la superficie plana, presionando ligeramente, durante 10 segundos. No restregar.
- Muestreo Mínimo: La distribución microbiana agregada requiere utilizar al menos 5 placas de contacto por muestreo (para cada medio) distribuidas al azar, cubriendo . Un muestreo inferior genera resultados muy erróneos.
Para Control de Aire
- Introducir la placa ENVIROCOUNT® en un aparato de muestreo de aeroplancton (se recomienda MICROFLOW®).
- Aspirar el volumen de aire deseado y cambiar la placa.
- Recomendación: Una placa por dependencia puede ser suficiente si se ajusta bien el volumen de aire en función de la experiencia previa.
Conservación y Caducidad
- Estabilidad: Las placas se conservan mejor sin oscilaciones de temperatura. Elija conservarlas en nevera () o a temperatura ambiente (), pero evite cambios constantes.
- Error Común: El frío deseca los medios no herméticos. Las placas exudan agua en la nevera, lo que acorta su caducidad por deshidratación.
- Caducidad Garantizada: desde la fabricación, prolongable hasta o hasta la pérdida del menisco (indicador de desecación) si se conservan en ambiente de temperatura homogénea.
- Pedidos: El pedido mínimo para un medio es de unidades. Para evitar demoras de hasta días, recomendamos establecer pedidos programados con su consumo anual.
Advertencia de Seguridad: La destrucción de los microorganismos tras el uso es responsabilidad del usuario según la legislación vigente (se recomienda inmersión en lejía). Mantener en la oscuridad y fuera del alcance de los niños.
Para cualquier consulta o aclaración de ENVIROCOUNT (PLACAS RODAC) o cualquiera de nuestra amplia gama de productos no dude en ponerse en contacto con nosotros en el teléfono (91)897 46 16 o el correo microkit@microkit.es.
https://www.microkit.es/pdf/Envirocount.pdf
https://www.microkit.es/monograficos/6-Control-de-superficies-monograf–a.pdf

Hola! actualmente trabajo con placas de contacto de la marca Scharlab de 55 mm de diámetro, el proveedor me indica que cualquier crecimiento debe ser multiplicado por 1000 para saber cual es la biocarga real, esto debido a que las placas RODAC presentan un factor de eficiencia de recobro de 0.1%
Agradeciendo de antemano las atenciones quisiera saber si ENVIROCOUNT MICROKIT también posee un factor de eficiencia de recobro, si es así ¿cual es el valor de este factor? o ¿cual seria la manera de interpretar los resultados?
Buenos días
Respondemos a su consulta desde nuestro correo general.
Muchas gracias por visitar nuestro blog y contactar con nosotros. Un cordial saludo.
BUEN DIA ME PUEDEN AYUDAR CON UNA COTIZACION DE LAS PLACAS RODAC CON MEDIO TSA- PENASA
SIN MAS QUEDO ATENTA A SUS COMENTARIOS
.
SALUDOS CORDIALES
Buenos días
Respondemos a su consulta desde nuestro correo general.
Muchas gracias por visitar nuestro blog y contactar con nosotros. Un cordial saludo
Necesito placas rodac para mi tesis.. necesito informacion por favor dejo mi correo
Buenos días
Respondemos a su consulta desde nuestro correo general.
Muchas gracias por visitar nuestro blog y contactar con nosotros. Un cordial saludo
Hola nosotros estamos recien utilizando las placas rodac y queremos saber cual es el tiempo de contacto para hacer mediciones a la vestimenta. Tambien saber como se expresan los resultados, ya que este tema es nuevo para nosotros.
Gracias.
Buenos días:
Respondemos su consulta desde nuestro correo general.
Muchas gracias por por visitar nuestro blog y contactar con nosotros.
Un cordiasl saludo.
Buenos días,
solicito medios de cultivos (placas preparadas)
Agar Métodos Estándar
Agar m-ENDOLES
Agar m-Green
Gracias, SALUDOS!
Buenos días,
Respondemos su consulta desde nuestro correo general. Muchas gracias por visitar nuestro blog y contactar con nosotros.
Un cordial saludo